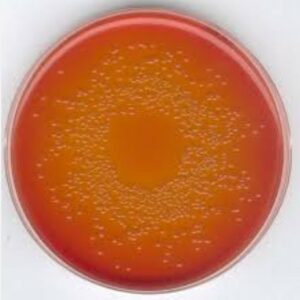

Môi Trường Nuôi Cấy MacConkey Agar 105465 Merck
Mã sản phẩm: 105465
Thương hiệu: Merck – Đức
Xuất xứ: Đức
Môi Trường Nuôi Cấy MacConkey Agar 105465 Merck là môi trường nuôi cấy khô, có tính chọn lọc và phân biệt đối với vi khuẩn Gram âm, đặc biệt là để phân lập Salmonella, Shigella và coliform. Các đặc điểm chính bao gồm khả năng ức chế vi khuẩn Gram dương bằng muối mật và tinh thể tím, sử dụng màu đỏ trung tính làm chỉ thị pH để phân biệt vi khuẩn lên men lactose (khuẩn lạc hồng/đỏ) với vi khuẩn không lên men (khuẩn lạc không màu), và tuân thủ các tiêu chuẩn EP, USP và JP đã được thống nhất.
- Mô tả
Mô tả
Môi Trường Nuôi Cấy MacConkey Agar 105465 Merck
Môi Trường Nuôi Cấy MacConkey Agar 105465 Merck, một môi trường nuôi cấy chọn lọc và phân biệt được sử dụng để phân lập vi khuẩn Salmonella, Shigella và coliform.
Chi tiết sản phẩm Môi Trường Nuôi Cấy MacConkey Agar 105465 Merck
- Thương hiệu: Merck (thuộc thương hiệu khoa học đời sống Sigma-Aldrich)
- Mã số danh mục:
105465.0500: Gói 500 g
105465.5000: Gói 5 kg - Định dạng: Bột khô/hạt trung bình
- Tuân thủ: Phương pháp hài hòa của Dược điển Châu Âu (EP), Dược điển Hoa Kỳ (USP) và Dược điển Nhật Bản (JP) để kiểm tra vi sinh vật trên các sản phẩm không vô trùng.
- Bảo quản: Bảo quản khô ráo, đậy kín ở nhiệt độ từ +15 đến +25 °C, tránh ánh sáng.
Nguyên lý và Cơ chế hoạt động Môi Trường Nuôi Cấy MacConkey Agar 105465 Merck
Thạch MacConkey là môi trường chọn lọc và phân biệt nhờ thành phần của nó:
- Các tác nhân chọn lọc: Muối mật và tinh thể tím ức chế đáng kể sự phát triển của vi khuẩn Gram dương.
- Các tác nhân phân biệt: Lactose (nguồn đường) và đỏ trung tính (chỉ thị pH) được sử dụng để phát hiện sự phân hủy lactose (lên men).
- Kết quả:
– Vi khuẩn lên men lactose (ví dụ: Escherichia coli, Klebsiella, Enterobacter) tạo ra axit, làm giảm pH và hình thành các khuẩn lạc màu hồng đến đỏ, thường có một vùng muối mật kết tủa (vầng sáng đục) xung quanh.
– Vi khuẩn không lên men lactose (ví dụ: Salmonella, Shigella) phát triển thành các khuẩn lạc không màu hoặc trong suốt.
Chuẩn bị Môi Trường Nuôi Cấy MacConkey Agar 105465 Merck
Để chuẩn bị môi trường từ bột, hòa tan 50 g trong 1 lít nước cất. Đun sôi cho tan hoàn toàn, sau đó khử trùng bằng cách hấp ở 121 °C trong 15 phút.










